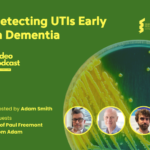
Podcast – Detecting UTIs Early in Dementia

Name:

Adam Smith
Adam Smith
Job Title:
Programme Director
Place of work / study:
NIHR Dementia Biomedical Research Centre at University College London
Area of Research:
Alzheimer's Disease and Dementias / Support for Early Career Researchers / Innovations in Public Engagement and Study Recruitment
How is your research funded:
National Institute for Health Research
Tell us about your career path to becoming an early career researcher.
I have worked on a number of healthcare innovation programmes over my 24 year career in healthcare, working within the NHS, Department of Health, commercial sector and at University College London for the past 13 years. I have previously worked on addressing challenges in healthcare associated infections, particularly MRSA, patient waiting times and healthcare reconfiguration and over the past few years I have entirely focused on dementia and have led various programmes and research studies, looking at improving study recruitment (leading on the development of Join Dementia Research), better supporting care homes and residents to engage with research (with the Enabling Research in Care Homes ENRICH, programme), and most recently leading on the creation development and delivery of this website, Dementia Researcher.
What does your research focus on?
For the past few years my own research has focused on public engagement in research, and challenges for early career research careers. I am also a member of the Health Research Authority National Research Ethics Panel, a Research Associate at the University of Sydney, Mentor and I sit on numerous advistory groups exploring healthcare improvement and innovation and other areas like early diagnosis of dementias.
Do you have any advice for someone looking to embark on a career in dementia research?
My advice would vary depending upon what you want out of your career. For those that are keen to get a fellowship or a lectureship, then I would say that early planning is essential. You need to think about what research you want to be doing independently, and work towards building a track record. Rightly or wrongly, papers are a key factor in progression. But more than where you publish, developing a strong track record within a specific area helps for funding. Second, be aware of opportunities for funding at all career levels. Being able to find funds to develop your own research is tough, but opportunity is out there. Also, network with people that want to help you and work with you. By talking to senior researchers, many will be able to help you develop your ideas or even help with experiments. I’ve always been surprised at how many people were willing to help me. Networking is key as an ECR; at that point in your career, you can’t do it alone.
What are the best bits about being a researcher?
There is still so much to learn about the brain and dementia, which makes it a fantastically exciting field to work in. Not just in bench science, but also in understanding how best to provide care, prevention and early diagnosis. With so many discoveries to be made, it is still possible to carve out your own path, to be unique and to make a real difference to the lives of people living with dementia right now, and to help future generations.
What do you see as the main challenges?
As I write this, we are in the middle of a global pandemic. As a result, some of the usual challenges around funding and career stresses are amplified. Effects on the economy, leaving the EU (for those of you UK based), and financially challenged charities are all creating a a great deal of uncertainty. However, dementia is finally getting the prioritisation it deserves. So while it may be a little harder to get grant funding, I do feel we as 'dementia researchers' are better positioned than most, to weather the storm. Pandemics and funding aside, this can be a tricky career choice for those who like job security and certainty in their lives. However, times are changing and with a academic institutions, the NHS and researcher funders now considering how they can improve early career researcher contracts, I do hope things will improve, making this a viable long-term career option for more people - to keep us working in the science we chose, and love.
Why did you choose to work in dementia?
I am particularly motivated when there is a direct line of sight between my work and improving the lives of patients. Dementia presents a particular challenge, and while I don’t have any personal experience of loss from this terrible disease, I have met many people living with dementia and their carers, and I wanted to do all I could to help.
What do you write about?
As the creator of this website, I regularly host podcasts talking about ECR career topics, and individuals research. My personal blogs are usually on topics I feel passionate about, particularly public engagement in research.
Tell us a fun fact about yourself:
I restore classic cars in my spare time, and currently hold a Guinness world record, as the organiser of the longest parade of Mini cars (1450), a record that has stood for the past 10 years.